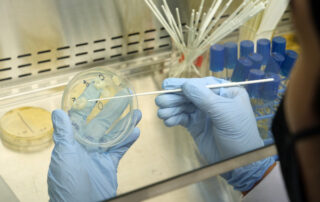
2022 Oak Crest
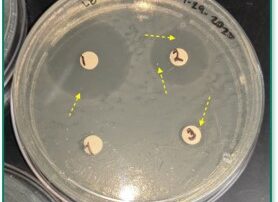

Student News
Below is a chronological listing of all news of interest to students and educators. To read about the experiences and benefits students get out of our programs, check out the Alumni News!
Pathway to STEM now accepting applications
The Pathways to STEM program is now accepting applications (click here to apply)! Pathways ...
MOST-IP welcomes CRISPR Classroom
We are excited to announce that CRISPR Classroom has joined MOST-IP: The Monrovia - ...
City of Monrovia Receives Award of Excellence for Youth Employment Services (YES) Program
City of Monrovia Receives Award of Excellence Monrovia, California - The California Park & Recreation ...
Announcing the 2022 Oak Crest Entrepreneur Fellowships (OCEF)
We are announcing the start of the Oak Crest Entrepreneur Fellowships (OCEF), a new 1-year ...
An Overview of COVID-19 Testing
An Overview of COVID-19 Testing Step 1: COVID-19 RNA Extraction RNA extraction is the ...
Spray Drying in the Pharmaceutical Industry
Spray Drying in the Pharmaceutical Industry The Oak Crest Institute of Science is making ...
Antibiotic Susceptibility Testing & Resistance
Antibiotic Susceptibility Testing Antibiotics are chemicals that inhibit bacterial growth (1). Antibiotic susceptibility testing ...
Junior Researcher Academy at Home 2021 ends with a great event
This summer 2021, the Oak Crest Institute of Science and the City of Monrovia ...
The 2021 virtual Junior Researcher Academy is underway!
Today was the first day of the Junior Researcher Academy in collaboration with the City ...